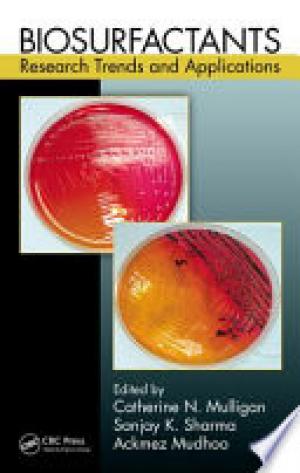
Biosurfactants : research trends and applications

Publisher: CRC Press
Found 34 books in total
2018,
Phytochemicals are the mainstay of therapeutics of herbal or botanical medicine....
2014,
This book reviews current knowledge and the latest advances, strategies for improving...
2012,
Knowledge of pharmacokinetics is critical to understanding the absorption,...
2013,
The potential that biomass energy has to supplement traditional fuels and reduce...
2014,
The purpose of this book is to discuss several medicinal plants to find wider...
2014,
This book underlines the importance of reciprocal interactions between probiotics and...
2013,
The present work evaluates the toxic effects of some environmental stressors on fish...
2014,
Cloud Computing and Digital Media: Fundamentals, Techniques, and Applications presents...
2013,
Written with a diverse audience in mind, this book describes the current status,...
2007,
The evolution of toxicology testing finds its impetus in the continuing growth of the...
2008,
Forget the idea that the food and beverage (F&B) industry is low-tech and...
2008,
Hybrid Simulation deals with a rapidly evolving technology combining computer...
2008,
Intelligent and adaptive techniques are rapidly being used in all stages of medical...
2007,
The global shift toward delivering services online requires organizations to evolve...
2012,
The third edition of the bestselling Clinical Trials in Oncology provides a concise,...
2001,
A survey of the extensive field of sucrose alternatives, detailing scientific...
2008,
The Use and Fate of Pesticides in Vegetable-based Agro-ecosystems in Ghana reviews...
2012,
Specialty foods are made from high quality ingredients and offer distinct features to...
2011,
As a growing number of healthcare organizations implement project management...
2006,
Lean? Six Sigma? or Lean Six Sigma? Which is the right approach for effective...
2012,
Sweeteners: Nutritional Aspects, Applications, and Production Technology explores all...
2012,
Flavonoids exert a multiplicity of biological effects on humans and can have...
2012,
A large variety of food products all over the world are prepared by the fermentation...
1997,
Furnishing the latest interdisciplinary information on the most important and...
Books per page: